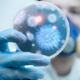
Senzacionalno odkritje ali opozorilo: odkrili 5000 let star sev bakterije, odporen na antibiotike

Prostor ima pestro zgodovino, ki sega vse do srednjega veka.👇 Ob Vodnikovi cesti v ljubljanski Šiški danes stoji zdravstveni objekt, ki deluje pod okriljem Kliničnega centra – Bolnica dr. Petra … · Metropolitan.si · 3d
spomini bolnica petra držaja zgodovina grad jama ljubljana objavi tvitaj

Vsako leto 24. marca obeležujemo svetovni dan tuberkuloze, datum pa predstavlja zgodovinski mejnik iz leta 1882, ko je nemški zdravnik in mikrobiolog Robert Koch odkril povzročitelja te bolezni – bakterijo … · Dnevnik · 1t

Tuberkuloza ni odnesla le Dragotina Ketteja in Josipa Murna, temveč tudi Georgea Orwella, ki pa je na srečo živel še ravno toliko časa, da je – leta 1948, v globoki … · Mladina · 4t

Ko nas empirična izkušnja prepriča, je to samo dobrodošel pripomoček za bodoče odločitve in ravnanja. Namen cepljenja je priprava organizma na obrambo ob morebitni okužbi. V srednjem veku so alkemijo … · Večer · 1M

V ZOO Ljubljana se veselijo novega člana šimpanzje družine. 27-letna šimpanzinja Neža, hčerka karizmatične Mojce, je namreč tretjič postala mama. Z 38-letnim samcem Borisom, ki je v Ljubljano prišel iz … · 24ur · 1M

V romunski ledeni jami so našli 5.000 let stare bakterije, odporne na številne sodobne antibiotike. Kot poroča Euronews , so raziskovalci v globinah ledene jame Scrioara odkrili sev Psychrobacter SC65A.3, … · Vizita.si · 1M
Že nekaj časa je znano, da bakterije v ekstremnih razmerah, kot so starodavne plasti ledu, permafrost, morsko dno ali ledeniška jezera, lahko preživijo tisočletja. Znanstveniki pravijo, da te bakterije živijo … · Dnevnik · 1M